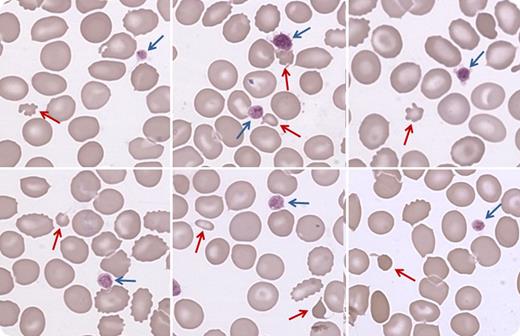
A 7-year-old girl affected by β-thalassemia minor was referred to us for the presence of wandering platelet counts. Platelet count was normal at the age of 2. At the age of 5, she presented with easy bruising and 30 × 109 platelets per L. Bleeding tendency disappeared spontaneously in a few weeks, and platelet count increased to 80 × 109/L. Subsequently, platelet counts measured in different laboratories fluctuated unpredictably from 80 to 250 × 109/L. EDTA-dependent pseudothrombocytopenia was excluded, and platelet counting by microscopy in a Neubauer chamber and by an optical cell counter revealed that the patient had 85 × 109 platelets per L. At variance, an impedentiometric counter gave 168 × 109 platelets per L in the same blood sample. Examination of blood films showed the presence of a few very small erythrocytes or fragments of erythrocytes (red arrows) with a size similar to that of platelets (blue arrows), which were a little larger than normal. Microerythrocytes were 1.7% of red cells (absolute count 96 × 109/L). / We concluded that most small red cells had been counted as platelets by the impedentiometric counter. After excluding secondary thrombocytopenias, we diagnosed a mild immune thrombocytopenia that, with some cell counters, was masked by the presence of very small erythrocytes.

A 7-year-old girl affected by β-thalassemia minor was referred to us for the presence of wandering platelet counts. Platelet count was normal at the age of 2. At the age of 5, she presented with easy bruising and 30 × 109 platelets per L. Bleeding tendency disappeared spontaneously in a few weeks, and platelet count increased to 80 × 109/L. Subsequently, platelet counts measured in different laboratories fluctuated unpredictably from 80 to 250 × 109/L. EDTA-dependent pseudothrombocytopenia was excluded, and platelet counting by microscopy in a Neubauer chamber and by an optical cell counter revealed that the patient had 85 × 109 platelets per L. At variance, an impedentiometric counter gave 168 × 109 platelets per L in the same blood sample. Examination of blood films showed the presence of a few very small erythrocytes or fragments of erythrocytes (red arrows) with a size similar to that of platelets (blue arrows), which were a little larger than normal. Microerythrocytes were 1.7% of red cells (absolute count 96 × 109/L).
We concluded that most small red cells had been counted as platelets by the impedentiometric counter. After excluding secondary thrombocytopenias, we diagnosed a mild immune thrombocytopenia that, with some cell counters, was masked by the presence of very small erythrocytes.
A 7-year-old girl affected by β-thalassemia minor was referred to us for the presence of wandering platelet counts. Platelet count was normal at the age of 2. At the age of 5, she presented with easy bruising and 30 × 109 platelets per L. Bleeding tendency disappeared spontaneously in a few weeks, and platelet count increased to 80 × 109/L. Subsequently, platelet counts measured in different laboratories fluctuated unpredictably from 80 to 250 × 109/L. EDTA-dependent pseudothrombocytopenia was excluded, and platelet counting by microscopy in a Neubauer chamber and by an optical cell counter revealed that the patient had 85 × 109 platelets per L. At variance, an impedentiometric counter gave 168 × 109 platelets per L in the same blood sample. Examination of blood films showed the presence of a few very small erythrocytes or fragments of erythrocytes (red arrows) with a size similar to that of platelets (blue arrows), which were a little larger than normal. Microerythrocytes were 1.7% of red cells (absolute count 96 × 109/L).
We concluded that most small red cells had been counted as platelets by the impedentiometric counter. After excluding secondary thrombocytopenias, we diagnosed a mild immune thrombocytopenia that, with some cell counters, was masked by the presence of very small erythrocytes.
For additional images, visit the ASH IMAGE BANK, a reference and teaching tool that is continually updated with new atlas and case study images. For more information visit http://imagebank.hematology.org.
This feature is available to Subscribers Only
Sign In or Create an Account Close Modal